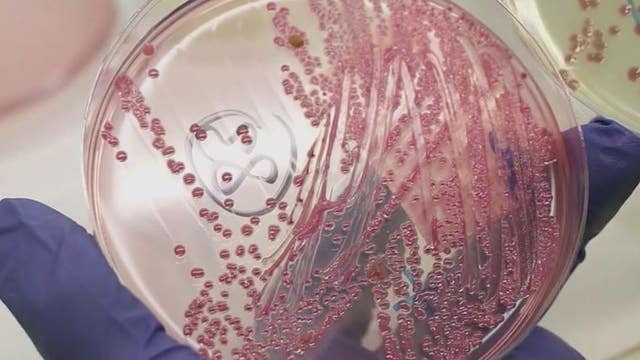
High levels of E. coli reported at Waukegan beaches

Waukegan Township holding gas card lottery for seniors
Although gas prices are down 70 cents from last month, many people are still feeling the pain at the pump.
Although gas prices are down 70 cents from last month, many people are still feeling the pain at the pump.
Waukegan Township giving out gas gift cards to help seniors amid high prices
Waukegan Township is looking to help senior residents deal with record high gas prices with a gift card lottery.
Waukegan Township is looking to help senior residents deal with record high gas prices with a gift card lottery.
Waukegan Township holding gas card lottery for senior residents
Waukegan Township is looking to help senior residents deal with record high gas prices with a gift card lottery.
Waukegan Township is looking to help senior residents deal with record high gas prices with a gift card lottery.
8 shot, 1 fatally, in three shootings overnight in Lake County
Police, firefighters and hospital personnel in Lake County were busy overnight after eight people were shot, one fatally, in three major shootings in Waukegan and North Chicago.
Police, firefighters and hospital personnel in Lake County were busy overnight after eight people were shot, one fatally, in three major shootings in Waukegan and North Chicago.
Planned Parenthood partnership to increase abortion access
Planned Parenthood announced a new partnership Thursday to bring health care professionals to Illinois to help with the increasing demand for abortions.
Planned Parenthood announced a new partnership Thursday to bring health care professionals to Illinois to help with the increasing demand for abortions.
3 victims killed in Highland Park parade shooting laid to rest
A former synagogue preschool teacher and two beloved grandfathers killed in the Highland Park parade shooting on the Fourth of July were laid to rest Friday.
A former synagogue preschool teacher and two beloved grandfathers killed in the Highland Park parade shooting on the Fourth of July were laid to rest Friday.
High levels of E. coli reported at Waukegan beaches
A bit of a letdown if you were planning to cool off with a swim in Lake Michigan.
A bit of a letdown if you were planning to cool off with a swim in Lake Michigan.
Man arrested after Lake County Sheriff's K9 finds over 2 kilograms of cocaine during traffic stop
A man faces drug charges after a Lake County Sheriff's canine found over two kilograms of cocaine during a traffic stop.
A man faces drug charges after a Lake County Sheriff's canine found over two kilograms of cocaine during a traffic stop.
North Chicago man killed when his motorcycle collides with Waukegan ambulance
The motorcycle driver was identified as 23-year-old Donald Stallworth III.
The motorcycle driver was identified as 23-year-old Donald Stallworth III.
Waukegan crash: 1 killed, 3 injured in head-on vehicle collision
The driver of the Ford crossed the double-yellow median markings in the center of the road, and drove into the northbound lanes of traffic, authorities said. The Ford struck a Toyota Camry head-on, killing a passenger in the Toyota.
The driver of the Ford crossed the double-yellow median markings in the center of the road, and drove into the northbound lanes of traffic, authorities said. The Ford struck a Toyota Camry head-on, killing a passenger in the Toyota.
Earth Week kicks off with events around Chicago area
Earth Week has kicked off with many events around the Chicago area leading up to Earth Day on April 22.
Earth Week has kicked off with many events around the Chicago area leading up to Earth Day on April 22.
Gunman opens fire on vehicle in Waukegan, 2 bystanders wounded
Two bystanders were wounded Sunday night when the occupant of a pickup truck opened fire on another vehicle in north suburban Waukegan.
Two bystanders were wounded Sunday night when the occupant of a pickup truck opened fire on another vehicle in north suburban Waukegan.
Lack of demand prompts closure of several COVID-19 testing sites in the Chicago suburbs
Demand for COVID-19 testing is down so sharply that the Illinois Department of Public Health is shutting down several community-based testing sites at the close of business Thursday.
Demand for COVID-19 testing is down so sharply that the Illinois Department of Public Health is shutting down several community-based testing sites at the close of business Thursday.
Illinois and Chicago cutting back on COVID-19 testing and vaccinations
Also on Friday, Illinois will close ten community-based COVID testing sites across the state, impacting five clinics in the Chicago area: Arlington Heights, Aurora, Harwood Heights, South Holland and Waukegan. At one point those sites were each testing more than a thousand people a day, but now that number is down to less than 50.
Also on Friday, Illinois will close ten community-based COVID testing sites across the state, impacting five clinics in the Chicago area: Arlington Heights, Aurora, Harwood Heights, South Holland and Waukegan. At one point those sites were each testing more than a thousand people a day, but now that number is down to less than 50.
Illinois and Chicago cutting back on COVID-19 testing and vaccinations
On Friday, Illinois will close ten community-based COVID testing sites across the state, impacting five clinics in the Chicago area: Arlington Heights, Aurora, Harwood Heights, South Holland and Waukegan. At one point those sites were each testing more than a thousand people a day for coronavirus, but now that number is down to less than 50. Dane Placko reports.
On Friday, Illinois will close ten community-based COVID testing sites across the state, impacting five clinics in the Chicago area: Arlington Heights, Aurora, Harwood Heights, South Holland and Waukegan. At one point those sites were each testing more than a thousand people a day for coronavirus, but now that number is down to less than 50. Dane Placko reports.
Jay Leno performs at Genesee Theatre in Waukegan
Legendary comedian and game show host Jay Leno continues a legacy of laughter. More than 1,800 fans saw Leno at Waukegan’s historic Genesee Theatre Friday night.
Legendary comedian and game show host Jay Leno continues a legacy of laughter. More than 1,800 fans saw Leno at Waukegan’s historic Genesee Theatre Friday night.
Jay Leno performing at Genesee Theatre in Waukegan
Jay Leno is in town! He performed at the Genesee Theatre in the Chicago suburbs.
Jay Leno is in town! He performed at the Genesee Theatre in the Chicago suburbs.
Woman found guilty of Waukegan fatal hit-and-run that killed Kenosha father
The jury found that Linda Ray knew she hit Chad Aiello, a father of one, and did not remain on the scene.
The jury found that Linda Ray knew she hit Chad Aiello, a father of one, and did not remain on the scene.
Waukegan launches new spring break programs for kids
Spring break will be here before you know it, which means many parents will soon be looking for something to do with their kids.
Spring break will be here before you know it, which means many parents will soon be looking for something to do with their kids.
Chicago-area company sold unapproved drugs that claimed to treat diseases, including cancer: prosecutors
A Waukegan-based company has been ordered to stop distributing nutritional supplements that they claimed would cure, treat or prevent various diseases including cancer.
A Waukegan-based company has been ordered to stop distributing nutritional supplements that they claimed would cure, treat or prevent various diseases including cancer.